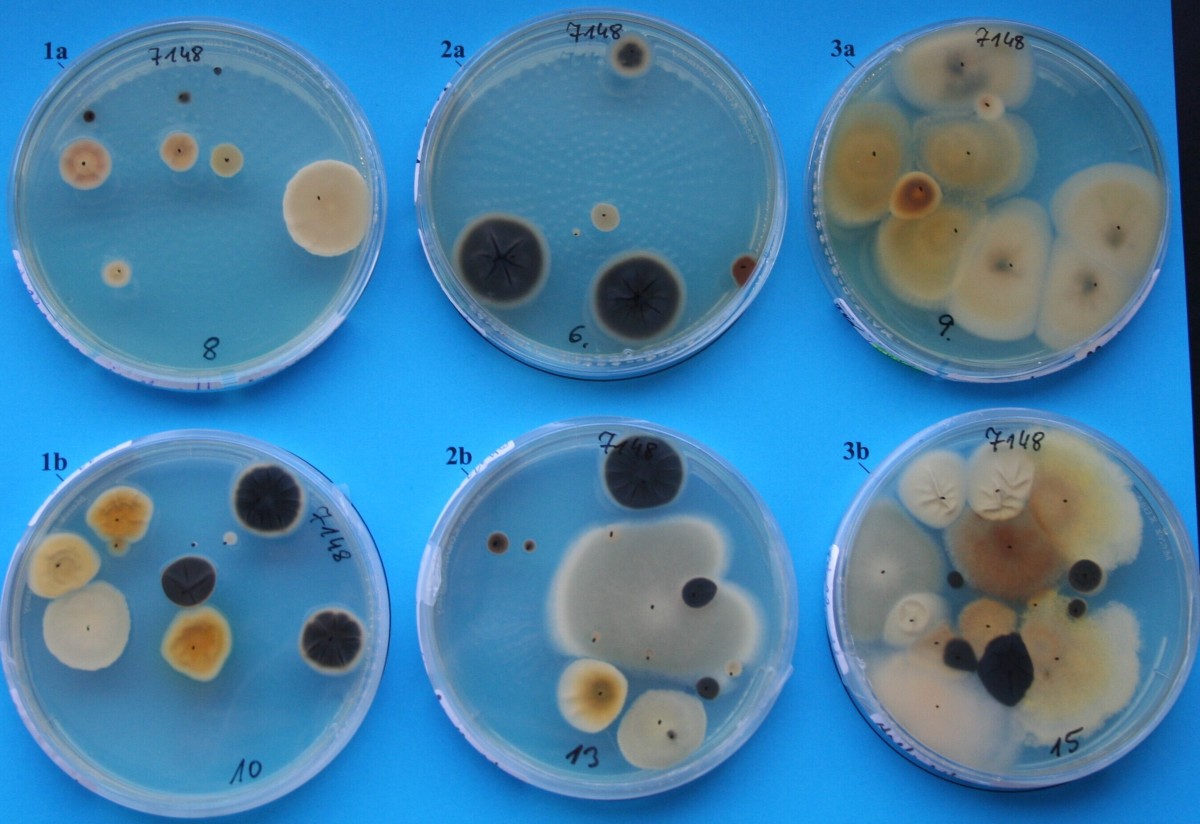
Kfz Luftproben auf Nährboden

Neuer Hygiene-Standard schafft Sicherheit
Vorfahrt für gesunde Luft im Auto: Vor dem Urlaub an die Klimaanlagen-Reinigung denken!
Wolfratshausen,30. Juli 2024
Sommer, Wärme, Reisezeit. Wer auf eigener Achse entspannt in die Ferien starten möchte, muss im Vorfeld einiges bedenken. Sind beispielsweise Reifendruck, Ölstand und Scheibenwaschanlage überprüft? Falls „ja“, steht dem Start in die schönste Zeit des Jahres vermeintlich nichts im Wege. Was allerdings gerne vergessen wird: die Wartung und die professionelle Reinigung der Klimaanlage. Denn schon lange, bevor unangenehme Gerüche entstehen, kann sie bereits so verschmutzt sein, dass sie die Autoinsassen beeinträchtigt. Feinstaub, gesundheitsschädliche Bakterien oder Schimmelpilzsporen, die durch die Klimaanlage ins Fahrzeuginnere gelangen, können auch für gesunde Menschen gefährlich werden. Der Verein Deutscher Ingenieure (VDI) und der Zentralverband Deutsches Kraftfahrzeuggewerbe (ZDK) haben daher den Hygiene-Standard für Klimaanlagen im Auto neu definiert. Der Tipp für alle Autofahrer: Beim Klimaanlagen-Check nicht nur den Innenraumluftfilter austauschen, sondern das gesamte Klimaanlagen-System professionell reinigen lassen! Mit nur einem Werkstattbesuch reduzieren Autofahrer so das Risikopotenzial für die Insassen deutlich und nachhaltig. Für einen guten Start in den Urlaub.
Auf die Reinigung des gesamten Klimaanlagensystems kommt es an
Die überarbeitete Richtlinie VDI/ZDK 6032 orientiert sich am aktuellen Stand der Technik und trägt dazu bei, Gesundheitsgefahren aus dem Fahrzeuginnenraum zu verbannen und nachhaltig gesunde Luft im Auto sicherzustellen. VDI und ZDK empfehlen, mindestens einmal jährlich das gesamte Klimaanlagensystem zu reinigen. Das heißt: Vor dem Einsatz eines neuen Innenraumluftfilters sollte auch das Filtergehäuse professionell gereinigt werden. Dies gilt ebenso für den Klimaanlagen-Verdampfer: Da sich an dessen Lamellen durch das Abkühlen der Raumtemperatur Kondenswasser bilden kann, entsteht ein idealer Nährboden für Viren, Bakterien und Schimmelpilzsporen. Diese werden von der Klimaanlage dauerhaft in der Umgebung verteilt, wenn sie nicht richtig gewartet wird.
Die weit verbreitete Anwendung sogenannter „Klickdosen“ zählt laut einem aktuellen Feldtest von VDI und ZDK nicht zu den zielführenden Reinigungsmethoden. Sie seien weder effektiv noch verbesserten sie die Lufthygiene. Eine Reinigungsmethode, die hingegen die neuen Anforderungen von VDI und ZDK umsetzt, ist die airco well Klimaanlagen-Reinigung von Tunap. Das System setzt genau dort an, wo die Klimaanlage im Auto besonders anfällig für Schmutz und schädliche Mikroorganismen ist: Bei der Pollenfilterbox und dem Verdampfer. „Mit der Kombination aus Reinigungs-Chemie und Mechanik, wie wir sie mit unserem airco well Reinigungsverfahren anbieten, werden Verschmutzungen aus dem gesamten Klimaanlagen-System effektiv entfernt. Unsere Produkte reinigen hygienerelevante Bauteile wirksam, richtlinienkonform, material- und gesundheitsverträglich. Das heißt, Schluss mit schlechter Luft und Gerüchen und Vorfahrt für gesunde Luft im Auto“, erklärt Thomas Behrendt, Leiter Produktmanagement bei Tunap.
Auf der Website aircowell.com stehen zahlreiche Informationen zur professionellen Klimaanlagenreinigung zur Verfügung. Zudem beantwortet Tunap dort häufig gestellte Fragen zu Pollenfilter und Verdampfer, zum Reinigungsvorgang sowie zur Gesundheits- und Umweltverträglichkeit von airco well. Dort lässt sich auch die passende zertifizierte Werkstatt ganz in der Nähe finden.
airco well: Zertifiziert und geprüft
Das airco well Reinigungsverfahren erfüllt in Hinblick auf Ganzheitlichkeit, Wirksam-keit, Gesundheitsverträglichkeit und Praxistauglichkeit als einziges Verfahren nach-weislich die wissenschaftlich-technisch fundierten Kriterien der neuen Richtlinie VDI/ZDK 6032. Zudem hat airco well das Qualitätssiegel der Europäischen Stiftung für Allergieforschung (ECARF) erhalten, das Produkte und Dienstleistungen als geeignet für Allergiker:innen kennzeichnet. Der TÜV Thüringen bestätigt der Klimaanlagen-Reinigung airco well von Tunap, dass die Verdampfer-Reinigung mit dem airco well 994 Hygiene-Reiniger eine signifikante Erhöhung des Luftdurchsatzes bewirkt. Daraus resultiert eine verbesserte Kühlleistung der Klimaanlage bei geringerem Energieverbrauch.
Über die Tunap Group
Die Tunap Group zählt weltweit zu den Technologieführern in der Herstellung von Aerosolen, Schmierstoffen und Reinigern für industrielle und technische Anwendungen. Produkte von Tunap pflegen und schützen und kombinieren innovative Chemie mit hohem Nachhaltigkeitsanspruch. Rund 30.000 Kunden weltweit vertrauen bereits auf Produkte und Systeme von Tunap. Bekannte Lösungen sind das Klimaanlagen-Reinigungssystem „airco well“ sowie die Techniklinie „Tunap Sports“ für erstklassige Fahrradreinigung und -pflege. Tunap bietet Forschung, Entwicklung, Produktion und Vertrieb aus einer Hand. Seit fünf Jahrzehnten ist das Familienunternehmen zuverlässiger Partner der Industrie.
Die Tunap Group hat ihren Hauptsitz in Wolfratshausen. Weitere Produktionsstandorte sind Lichtenau bei Chemnitz und Märstetten in der Schweiz. Weltweit ist Tunap in 16 Märkten in Europa, Amerika und Asien mit eigenen Gesellschaften vertreten. Insgesamt beschäftigt die Tunap Group rund 700 Mitarbeitende und erzielt einen Jahresumsatz von rund 234 Millionen Euro.
Mehr über die Tunap Group und ihre innovativen Produkte und Konzepte erfahren Sie unter tunap.com.
Bildmaterial

Vorschlag Bildunterschrift:
Mit airco well schafft Tunap die Voraussetzungen für nachhaltig gesunde Atemluft im Auto.

Vorschlag Bildunterschrift:
Verdampfer (links) und Pollenfilterbox (rechts) vor und nach der Reinigung. Mit airco well werden Feinstaub, gesundheitsschädliche Bakterien und Schimmelpilze, die sich mit der Zeit in der Autoklimaanlage sammeln, effektiv und nachhaltig beseitigt.
Vorschlag Bildunterschrift:
Luftproben, die im Zuge eines Hygiene-Versuches der Firma Tunap auf einem Nährboden in einem Auto entstanden sind.
[Copyright alle Bilder: Tunap Group, Verwendung honorarfrei]
Das Pressematerial zu dieser Meldung
Die Adolf Würth GmbH & Co. KG erhebt und verarbeitet die in dem Formular angegebenen personenbezogenen Daten, um für Sie die gewünschte Anfrage zu bearbeiten. Bitte beachten Sie bei den Formularen die Markierung der Pflichtfelder. Rechtsgrundlage für diese Verarbeitung, der zwingend erforderlichen Daten, ist Art. 6 Abs. 1 lit. b DSGVO, Durchführung einer vorvertraglichen Maßnahme. Die Verarbeitung der von Ihnen freiwillig mitgeteilten Daten erfolgt auf der Grundlage von Art. 6 Abs. 1 lit. f DSGVO. Danach ist eine Verarbeitung zulässig, die zur Wahrung der unserer berechtigten Interessen erforderlich ist. Unser berechtigtes Interesse besteht darin, mit Ihnen, unseren Kunden, Kontakt zu haben, unsere Beratungsqualität zu verbessern und Sie bei möglichen Rückfragen einfacher kontaktieren zu können. Die erhobenen Daten werden von uns nur solange gespeichert, wie es für die Bearbeitung Ihrer Anfrage sowie zur Kontaktaufnahme mit Ihnen erforderlich ist. Danach werden sie gelöscht.
Ergänzende Datenschutzhinweise, insbesondere zu Ihren Rechten auf Auskunft, Berichtigung, Löschung, Einschränkung der Verarbeitung, Widerspruch und Beschwerde, finden Sie in unserer Datenschutzerklärung.
